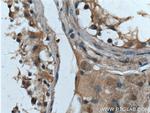
Bcl-XL Antibody in Immunohistochemistry (Paraffin) (IHC (P))

Search
Proteintech
Bcl-XL Polyclonal Antibody
{{$productOrderCtrl.translations['antibody.pdp.commerceCard.promotion.promotions']}}
{{$productOrderCtrl.translations['antibody.pdp.commerceCard.promotion.viewpromo']}}
{{$productOrderCtrl.translations['antibody.pdp.commerceCard.promotion.promocode']}}: {{promo.promoCode}} {{promo.promoTitle}} {{promo.promoDescription}}. {{$productOrderCtrl.translations['antibody.pdp.commerceCard.promotion.learnmore']}}
产品信息
26967-1-AP
种属反应
已发表种属
宿主/亚型
分类
类型
抗原
偶联物
形式
浓度
规格
纯化类型
保存液
内含物
保存条件
运输条件
产品详细信息
This antibody can recognize Bcl-XL, Bcl-XS and Bcl-X (Beta).
Immunogen sequence: MSQSNRELV VDFLSYKLSQ KGYSWSQFSD VEENRTEAPE GTESEMETPS AINGNPSWHL ADSPAVNGAT GHSSSLDARE VIPMAAVKQA LREAGDEFEL RYRRAFSDLT SQLHITPGTA YQSFEQVVN (1-128 aa encoded by BC019307 )
靶标信息
BCL-XL is a part of the BCL-2 protein family. BCL-2 family members form hetero- or homodimers and act as anti- or pro-apoptotic regulators that are involved in a wide variety of cellular activities. BCL-XL is located at the outer mitochondrial membrane, and have been shown to regulate outer mitochondrial membrane channel (VDAC) opening. VDAC regulates mitochondrial membrane potential and controls the production of reactive oxygen species and release of cytochrome C by mitochondria, both of which are the potent inducers of cell apoptosis. Two alternatively spliced transcript variants, which encode distinct isoforms, have been reported. The longer isoform acts as an apoptotic inhibitor and the shorter form acts as an apoptotic activator.
仅用于科研。不用于诊断过程。未经明确授权不得转售。
生物信息学
蛋白别名: anti-apoptosis regulatory protein; Apoptosis regulator Bcl-X; B-cell leukemia/lymphoma x; Bcl-2-like protein 1; bcl-xL; bcl-xS; Bcl2-L-1; BCLX; BCLXL; BCLXS; DKFZp781P2092; OTTHUMP00000030550; OTTHUMP00000030552; OTTHUMP00000030555; OTTHUMP00000030556; OTTHUMP00000030557; protein phosphatase 1, regulatory subunit 52; RP5-857M17.3; unnamed protein product
基因别名: Bcl(X)L; Bcl-X; Bcl-XL; BCL-XL/S; bcl2-L-1; BCL2L; BCL2L1; BCLX; PPP1R52
UniProt ID: (Human) Q07817, (Mouse) Q64373
Entrez Gene ID: (Human) 598, (Mouse) 12048